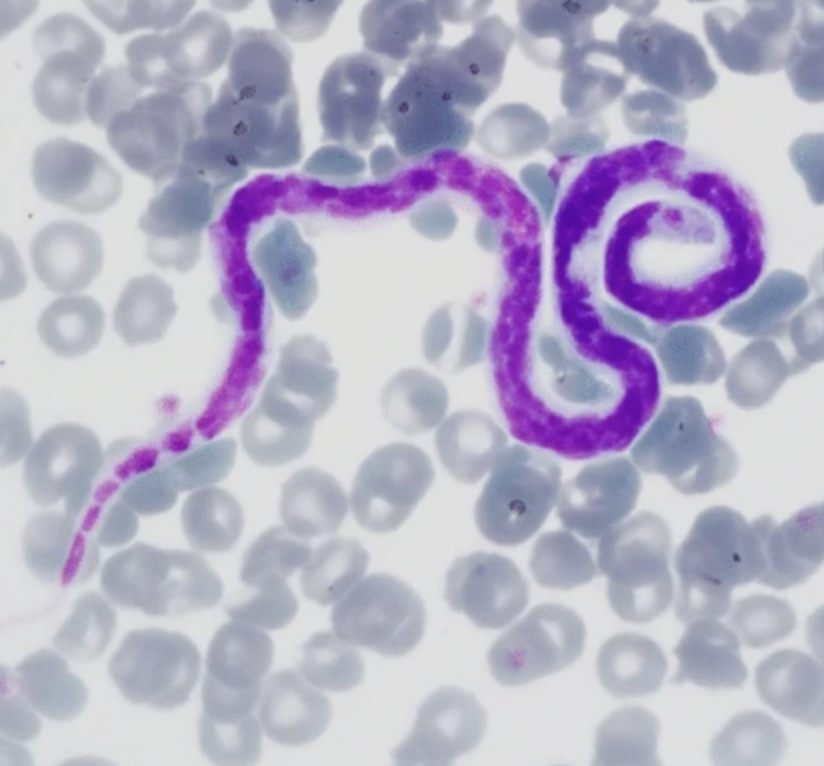

Veterinary Lab Techniques 15 Parasitology - Nematodes pt 2
Nematodes: A diverse group of roundworms known for their segmented bodies, which can inhabit a variety of environments including soil, marine, and freshwater ecosystems.
Common species include Ascaris (intestinal roundworm), Ancylostoma (hookworm), and Dirofilaria (heartworm).
Diagnosis typically involves fecal flotation, where nematode eggs are isolated from feces for microscopic examination. Other methods such as direct smear and Baermann technique may also be employed to identify the presence of adult worms or larvae in samples. Additionally, serological tests can assist in detecting antibodies or antigens associated with nematode infections, providing a more comprehensive diagnosis.
Treatment options for nematode infections often include anthelmintic medications, which are designed to target specific life stages of the worms, disrupting their metabolic processes. It is crucial to follow up with preventive measures, including regular deworming protocols and maintaining proper sanitation, to reduce the risk of future infections. Furthermore, educating pet owners about the signs of nematode infestations, such as weight loss, diarrhea, and lethargy, is essential for early detection and intervention. In summary, a multi-faceted approach combining accurate diagnostic techniques, effective treatment, and preventive strategies can significantly improve outcomes for pets affected by nematodes.
Threadworm
Strongyloides stercoralis
Threadworm
Strongyloides stercoralis
Definitive Host: Dogs, cats, and humans. This nematode is significant for its ability to infect multiple mammalian species, establishing itself as an important zoonotic pathogen.
Common Name: Intestinal threadworm.
Adults: Found primarily in the small intestine, these worms are transparent and relatively small, typically measuring around 2 mm in length.
Prepatent Period (PPP): The time from infection until diagnostic stages can be detected (larvae in feces) is approximately 8-14 days.
Mode of Infection
Infection with Strongyloides stercoralis can occur through several routes:
Skin penetration: The infective third-stage (L3) filariform larvae, found in contaminated soil, can actively penetrate the skin of susceptible hosts.
Ingestion of infective larvae: L3 larvae can also be ingested from the environment.
Direct Transmission via Larvated Egg: While less common for environmental infection, in some cases, infective larvae can develop within the egg rapidly, leading to direct transmission if ingested. Transmission via milk from an infected dam to offspring is also possible.
Life Cycle
Strongyloides stercoralis exhibits a complex life cycle that can involve both parasitic and free-living generations. The parasitic cycle typically unfolds as follows:
Ova hatch in intestine: Unlike most nematodes, the eggs of Strongyloides spp. are usually larvated and hatch rapidly within the host's intestine. The first-stage (L1) rhabditiform larvae are then passed in the feces (it's important to note that larvated eggs are generally not found in fresh feces; rather, the L1 larvae are passed).
Larvae migrate: Once L3 larvae infect a host (via skin penetration or ingestion), they migrate through the body. This often involves a tracheal migration route:
Larvae enter the bloodstream, travel to the lungs.
From the lungs, they move up the airway.
They are coughed up and then swallowed.
Finally, they reach the gastrointestinal (GI) tract where they mature into adult worms.
Autoinfection: A critical characteristic of Strongyloides is autoinfection (internal re-infection), where L1 larvae within the host's intestine can develop into L3 larvae, penetrate the intestinal wall or perianal skin, and re-enter the bloodstream without ever leaving the host. This mechanism can lead to chronic infections and, in immunocompromised individuals, potentially fatal hyperinfection syndrome.
Clinical Signs
Clinical signs can vary in severity and depend on the intensity of infection and host immune status:
Gastrointestinal signs: Severe diarrhea, often chronic, leading to weight loss and malabsorption. Vomiting and anorexia may also occur.
Respiratory signs: During larval migration through the lungs, animals and humans may exhibit coughing, wheezing, and other respiratory distress.
Dermatitis: Skin irritation or dermatitis can occur at the site of larval penetration.
Zoonotic Potential
Strongyloides stercoralis is highly zoonotic, being a major causative agent of strongyloidiasis in humans worldwide. Due to its autoinfection capability, human infections can persist for decades, and hyperinfection syndrome can be life-threatening.
Diagnosis
Diagnosis typically involves identifying L1 larvae in fresh fecal samples. Since eggs hatch rapidly, they are rarely seen.
Baermann technique: This method is highly effective for concentrating and detecting motile L1 larvae due to their active migration out of the fecal material.
Direct fecal smear: Can be used, but sensitivity is lower.
Fecal culture: Can be performed to allow L1 larvae to develop into L3 larvae for identification.
Treatment
Treatment usually involves anthelmintic medications such as ivermectin, fenbendazole, or moxidectin, depending on the host species and severity of the infection. Given the zoonotic and autoinfectious nature, follow-up testing and environmental sanitation are crucial.
Heartworm
Order: Rhabditida
Dirofilaria immitis

Definitive host: Primarily dogs, occasionally cats and ferrets
Intermediate host: Mosquito
Common name: Heartworm
PPP: 6-8 months
Adults:
Size: 15-25 cm long, found within the right ventricle and pulmonary artery.
Lifespan: 5-7 years in dogs; 2-3 years in cats.
Infections: New infections can occur during the patent period of existing infections.
Mode of Infection of Dirofilaria immitis
Infective Stage: L3 larvae are transmitted by mosquitoes that have fed on infected dogs.
Clinical Signs in Dogs
Related to heart conditions, including:
Syncope (fainting)
Sudden death
Coughing
Vomiting
Weight loss
Dyspnea (difficulty breathing)
Lethargy
Anorexia (loss of appetite)
Life Cycle of Dirofilaria immitis

Mosquito ingests microfilaria: When a mosquito feeds on an infected dog, it ingests microfilariae (L1 stage larvae) circulating in the dog's bloodstream. These microfilariae migrate to the mosquito's midgut.
Development in mosquito: Within the mosquito's Malpighian tubules, the microfilariae (L1) develop into L2 larvae and then into infective L3 larvae over approximately 10-14 days. Ideal conditions are around 27∘C27∘C (80∘F80∘F), with development arrested or slowed at lower temperatures.
Transmission: When the infected mosquito subsequently feeds on another dog, the infective L3 larvae are injected into the subcutaneous tissues of the new host through the mosquito's proboscis.
Molting to L4: The L3 larvae molt to the L4 stage within the subcutaneous tissues of the dog within 1-2 days (approximately 48 hours) post-infection.
Development into young adults: The L4 larvae continue to develop and migrate through the subcutaneous and muscle tissues, maturing into young adults over a period of 50-70 days.
Migration to heart and pulmonary arteries: These young adults then migrate via the venous circulation to the right ventricle of the heart and the pulmonary arteries, arriving approximately 70-120 days post-infection.
Maturation and growth: Upon arrival in the heart and pulmonary arteries, the young adults are typically about 2-4 cm long and rapidly grow to their adult size of 15-25 cm.
Reproduction and microfilariae release: Mature female worms in the pulmonary arteries begin to release new microfilariae (L1) directly into the bloodstream of the dog. This marks the beginning of the prepatent period (PPP), which commonly lasts 6-8 months, meaning it takes 6-8 months from the initial L3 infection until new microfilariae can be detected in the dog's blood.
Diagnosis in Dogs
ELISA Test: Enzyme-linked immunosorbent assay (Snap test)
Detects Dirofilaria antigen (from female worms over 6 months old).
High accuracy unless:
Only immature female worms are present
Very few adult parasites are present
Only males are present
Will not detect infections during the PPP.
Microfilariae Detection: Methods include:
Direct examination of fresh blood or blood treated with anticoagulant
Examination of liquid-cell interface (buffy coat) in a microhematocrit tube
Concentration via stained/unstained Millipore filter
Centrifugation modified Knott test (MKT).
Dirofilaria immitis in Cats
Infection Resistance: Cats show more resistance compared to dogs (considered atypical hosts).
Adult Worms: Generally have fewer than six adults present, typically of the same sex.
Diagnosis Challenges:
Often goes undiagnosed due to circulating microfilariae not typically found in cats (occult infections).
Even immature worms can cause lung damage.
Aberrant Migration and Clinical Signs in Cats
Aberrant migration of heartworms is more common in cats compared to dogs, potentially occurring in:
Body cavities
Systemic arteries
Central Nervous System
(CNS)
Clinical Signs:
Usually associated with the arrival of worms in pulmonary vasculature or the death of adult worms leading to sudden death.
Diagnosis in Cats
Difficulties: Due to typically non-patent infections (very few or no adult worms).
Testing Preference:
Antigen and antibody tests to detect exposure to heartworm larvae.
Chest radiographs to identify changes in vascular structures or parenchymal inflammation.
Ultrasound/Echocardiography to reveal the presence of heartworms.
Treatment
In Dogs: Melarsomine dihydrochloride (Adulticide).
In Cats: Treatment methods used for dogs cannot be utilized due to safety concerns.
Prevention is the primary means of protecting cats.
Goal: Stabilization through proper veterinary care.
Preventive Medications: Include Ivermectin, moxidectin, selamectin, and milbemycin oxime.
Nematodes Targeting the Respiratory System in Dogs and Cats…
Lungworm
Order: Metastrongyloidea
Aelurostrongylus abstrusus
Clinical Signs: Dogs and cats infected with lungworms may exhibit coughing, difficulty breathing, and potential weight loss due to reduced appetite. In severe cases, pneumonia may develop as a complication of the infection.
Transmission: Lungworms are typically transmitted through the ingestion of infective larvae found in contaminated environments or via intermediate hosts such as rodents. Preventative measures include maintaining good hygiene, regular deworming protocols, and monitoring the health of pets, especially those that spend time outdoors or have access to environments where infected hosts may be present.


Definitive host: Cats
Intermediate host: Gastropods (slugs or snails)
Common name: Feline lungworm
Adults: Size ranges from 4-9mm long (females are longer) and reside in the lungs.
PPP: 5-6 weeks.
Mode of Infection of Aelurostrongylus abstrusus
Infection Routes:
Ingestion of intermediate hosts (snails, slugs).
Ingestion of paratenic hosts (rodents, birds, frogs that have consumed intermediate hosts).
Life Cycle of Aelurostrongylus abstrusus

Life Cycle of Aelurostrongylus abstrusus
Eggs are laid by adult female worms and hatch in the lungs: Adult Aelurostrongylus abstrusus females, residing in the alveolar ducts and terminal bronchioles of the definitive host (cats), lay eggs in these locations. These eggs hatch within the cat's lungs.
Larvae are expelled: The first-stage larvae (L1) emerge from the hatched eggs in the lungs. These L1 larvae are then coughed up, swallowed, and subsequently passed through the intestinal tract, exiting the cat's body with the feces.
Gastropods ingest the larvae: Terrestrial gastropods (snails or slugs), acting as intermediate hosts, ingest the L1 larvae present in the cat's feces.
Development in the intermediate host: Inside the gastropod, the L1 larvae develop into second-stage (L2) larvae and then into infective third-stage (L3) larvae. This development typically takes about 2-4 weeks.
Cats become infected: Cats acquire the infection by consuming either an infected intermediate host (snail or slug) directly, or by consuming paratenic hosts (such as rodents, birds, or frogs) that have ingested infected gastropods.
Larvae migration in definitive host: Once ingested by the cat, the L3 larvae penetrate the intestinal mucosa. From there, they migrate through the cat's body, primarily via the lymphatic and circulatory systems, aiming for the respiratory system.
Adult worms develop and reside in the lungs: The migrating larvae eventually reach the lungs, where they mature into adult worms. These adult worms typically reside in the alveolar ducts and terminal bronchioles, completing the life cycle. The prepatent period (PPP) in cats is approximately 5-6 weeks from ingestion of L3 larvae until L1 larvae appear in the feces.
Diagnosis of Aelurostrongylus abstrusus
Techniques:
Baermann technique to locate first-stage larvae (L1).
Analyze fresh fecal samples (noting sporadic shedding).
Use bronchoalveolar lavage to recover fluids and look for L1s, identifiable by a “kinked tail.”
Clinical Signs of Aelurostrongylus abstrusus
Present as chronic cough, dyspnea (difficulty breathing), and wheezes.
Prevention: Efforts should be made to limit cats from hunting potentially infected rodents and gastropods (snails, slugs, etc.).
Zoonotic Potential: Not considered zoonotic.
Eucoleus (Capillaria) aerophila
Order: Enoplida
Eucoleus (Capillaria) aerophila
/


Habitat: Primarily found in the respiratory system of various mammals, including dogs and cats.
Symptoms: Infected animals may exhibit respiratory signs, including coughing, wheezing, and difficulty breathing. In severe cases, the presence of nematodes can lead to more serious conditions such as pneumonia or bronchitis, requiring prompt veterinary attention and treatment.
Transmission: Ingestion of eggs from contaminated soil or through the fecal-oral route.
Definitive host: Dogs and cats
Common name: Lungworm of dogs and cats, feline and canine bronchial capillarid
Adult worms range in size from 24-30mm and reside in the trachea, bronchi, and bronchioles.
PPP: 6-7 weeks.
Mode of Infection of Eucoleus (Capillaria) aerophila
Infection Routes:
Ingestion of infective ova found in sputum or feces.
Ingestion of paratenic hosts, such as infected earthworms.
Life Cycle of Eucoleus (Capillaria) aerophila

Eggs in sputum or feces are expelled (oral-fecal route).
Larvae from ingested eggs hatch in the small intestine and penetrate the mucosa, then migrate to the lungs via the bloodstream.
Clinical Signs: May be asymptomatic; however, heavy infestations lead to respiratory symptoms resulting from bronchiolitis and bronchitis (e.g., coughing, nasal discharge, dyspnea).
Diagnosis of Eucoleus (Capillaria) aerophila
Detection of Ova: Found in sputum or feces via:
Fecal flotation techniques.
Tracheal wash to extract samples.
Egg Morphology Distinction:
Eggs often confused with Trichuris (whipworm) eggs; notable differences include:
Size (smaller than T. vulpis)
Color (lighter)
Shape (more broadly barrel-shaped with asymmetric bipolar plugs).
Nematodes Targeting Dogs and Cats' Urinary System…
Bladder Worm
Order: Enoplida
Pearsonema plica & Pearsonema feliscati




Definitive host: Dogs (P. plica), Cats (P. feliscati)
Intermediate host: Annelids (Earthworms)
Common name: Bladder worm
PPP: Approximately 2 months
Adult Size: Ranging from 13-60mm, residing in the mucosa of the urinary bladder.
Egg Description: Barrel-shaped, colorless, with a thick striated shell and bipolar plugs.
Mode of Infection of Pearsonema plica & Pearsonema feliscati
Ingestion of infected earthworms or paratenic hosts is believed to lead to infection, possibly through soil containing macerated earthworms.
Life Cycle of Pearsonema plica & Pearsonema feliscati
Eggs are shed in the urine of the definitive host:
The adult male and female worms, which reside in the urinary bladder mucosa of the definitive host (dogs or cats), mate. Gravid female worms lay eggs that are passed in the definitive host's urine into the external environment. These eggs are unembryonated when shed.Development and ingestion by intermediate host:
In the external environment, under suitable conditions, the eggs embryonate, and first-stage larvae (L1) develop within them over approximately 30 days. These embryonated eggs are then ingested by an obligate intermediate host, an annelid (earthworm).Larval development in earthworm:
Inside the earthworm's alimentary canal, the L1 larvae hatch from the eggs, penetrate the intestinal wall, and migrate to the coelomic cavity of the earthworm. Here, they develop into infective third-stage (L3) larvae, typically over a period of 2-3 weeks.Definitive host infection:
The definitive host (dog or cat) becomes infected by ingesting an earthworm containing these infective L3 larvae. Infection can also occur if the definitive host consumes a paratenic host (e.g., small rodents, birds, frogs) that has previously ingested infected earthworms.Migration in definitive host:
Once ingested by the definitive host, the L3 larvae are released from the earthworm in the digestive tract. They penetrate the intestinal wall and embark on a migration route, primarily via the lymphatic and circulatory systems. The larvae eventually reach the kidneys and then descend through the ureters.Maturation in bladder:
Upon reaching the urinary bladder, the L3 larvae mature into adult male and female worms. These adult worms embed themselves in the mucosa of the urinary bladder, mate, and begin laying eggs, thereby completing the life cycle. The prepatent period (PPP), from the ingestion of L3 larvae to the detection of eggs in the urine, is approximately 2 months.
Diagnosis of Pearsonema plica & Pearsonema feliscati
Urine Sedimentation: Looking for amber, barrel-shaped, asymmetric bipolar plugged eggs (65 x 25 µm).
Clinical Signs: May be asymptomatic; possible signs of cystitis, dysuria, hematuria, and polyuria.
Treatment Options: Include Ivermectin and fenbendazole.
Giant Kidney Worm
Order: Ascaridida
Dioctophyme renale


Definitive hosts: Dogs, ferrets, otters, occasionally cats, horses, and cattle.
Intermediate hosts: Annelids.
Common name: Giant kidney worm.
Adult Location: Typically found in the right kidney; may also be free in the peritoneal cavity. Adults can be bright red and over a meter long.
PPP: 5 months.
Clinical Signs: Ranging from asymptomatic to hematuria and/or signs of renal dysfunction.
Zoonotic Potential: Yes, it can be transmitted to humans.
Mode of Infection of Dioctophyme renale
Infection Routes: Ingestion of intermediate hosts (e.g., earthworms) or paratenic hosts (frogs, fish, crayfish) that have themselves consumed intermediate hosts.
Lifecycle Migration: L3-stage larvae penetrate the stomach, migrate to the abdominal cavity, and ultimately settle in the right kidney.
Life Cycle of Dioctophyme renale

Infected definitive hosts produce eggs that are passed in urine.
Eggs are ingested by an annelid (intermediate host) and develop from L1 to L3.
Definitive hosts get infected by consuming L3 within the annelid or other paratenic hosts.
L3-stage larvae migrate to the abdominal cavity and settle in the right kidney.
Diagnosis of Dioctophyme renale
Testing Methods: Urine sediment tests for eggs which are dark brown and barrel-shaped, measuring 65 x 42 µm, and having opercula at both ends. The eggs possess thicker, pitted shells compared to Pearsonema spp.
Clinical Manifestations: Can destroy kidney parenchyma, potentially leaving only the capsule intact. Generally, asymptomatic; may find eggs incidentally during spaying. Possible signs: dysuria, hematuria, or lumbar pain. Other tests may include ultrasound and IV pyelography; treatment often necessitates surgical removal.
Parasites Targeting the Eyes of Dogs and Cats…
Eye Worm
Order: Spiruroidea
Thelazia spp.


Definitive hosts: Dogs, cats, and other mammals
Intermediate host: Drosophila flies (commonly known as fruit flies).
Common Names: Eyeworm
Adult Size: Ranges from 7-20mm long, appear white and exhibit rapid movement across the eye.
Adult Residence: Found in the conjunctival sac, tear ducts, conjunctiva, and under the nictitating membrane and eyelids.
PPP: 16-21 days.
Life Cycle of Thelazia spp.

Adult worms reside in the conjunctival sac of the definitive host.
Ovoviviparous females release L1 larvae.
L1 larvae are ingested by the intermediate host (fly) during feeding on tear fluid and lacrimal secretions.
Larvae develop to L3 in the intermediate host and migrate to the fly's mouthparts.
Upon the fly feeding on a new definitive host, the larvae invade the conjunctival sac and develop into adults.
Clinical Signs of Thelazia spp.
Symptoms include:
Lacrimation
Conjunctivitis
Photophobia (sensitivity to light)
Corneal opacity and ulceration.
Diagnosis of Thelazia spp.
Ova and Larvae Examination: Detection of ova and larvae through tears.
Treatment:
Use of local anesthetics for parasite removal with forceps.
Dewormers may also be applied to eliminate the infection.